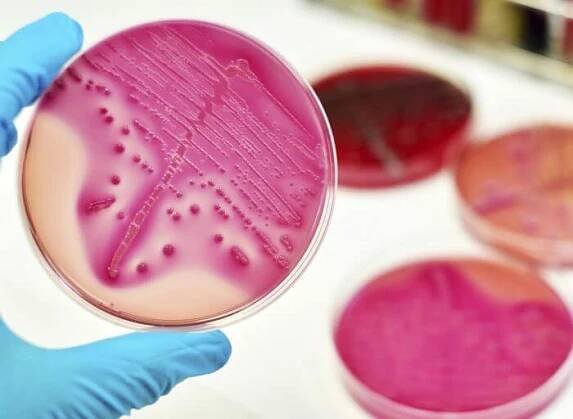

Mycobacterium avium subspecies paratuberculosis (MAP) je intracelulární patogen. Napadá v první řadě buňky imunitního systému. Vyskytuje se u všech savců včetně lidí, způsobuje fatální onemocnění, které lze draze a dlouhodobě léčit, ale nelze je zcela vyléčit. Paratuberkulóza má dlouhou inkubační dobu (3…
Komplex Mycobacterium avium u malých kníračů | Dle témat…
Komplex Mycobacterium avium u malých kníračů Dle témat Zvěrokruh 11/2021
Aviární mykobakteriózy u lidí – stále hrozící nebezpečí v České…
Zástupci komplexu Mycobacterium avium patří k nejčastěji prokazovaným původcům mykobakterióz u lidí. Jsou řazeni mezi podmíněně patogenní mykobakterie, přestože u ptáků (zejm. hrabavá drůbež) a savců (zejm.
Mycobacterium avium subsp. avium and Mycobacterium neoaurum…
Mycobacterium neoaurum was cultured repeatedly from his sputum and, Mycobacterium avium subsp. avium (M. a. avium) was detected by IS901 qPCR from detached fragments of his intestinal mucosa.
Mycobacterium avium paratuberculosis | Vetweb.cz – veterinární…
Původce paratuberkulózy způsobuje průjmy u psů
Nejasnosti kolem Mycobacterium avium subsp. paratuberculosis…
Druhé zasedání bylo výhradně věnováno živočišnému patogenu Mycobacterium avium subspecies paratuberculosis (Map). Uvedený organismus způsobuje Johnesovu chorobu u mnoha živočišných druhů, např. hovězího dobytka, ovcí, koní, koz, jelenů, losů…
Medvik: Mycobacterium avium komplex
Bakterie řazená k atypickým mykobakteriím. Vyvolává onemocnění ptáků, drůbeže, je přítomna ve vodě. U člověka je oportunním patogenem.
Medvik: Mycobacterium avium
Měl by být rozlišován od bakterií komplexu M. avium, které primárně infikují člověka.
Související dotazy
Nabídka ze Zboží.cz
Do 3 dnů
od 119 Kč
2 235 Kč
Dezishop.cz
odkazuje na služby nejen od Seznam.cz.
© 1996–2025 Seznam.cz, a.s.